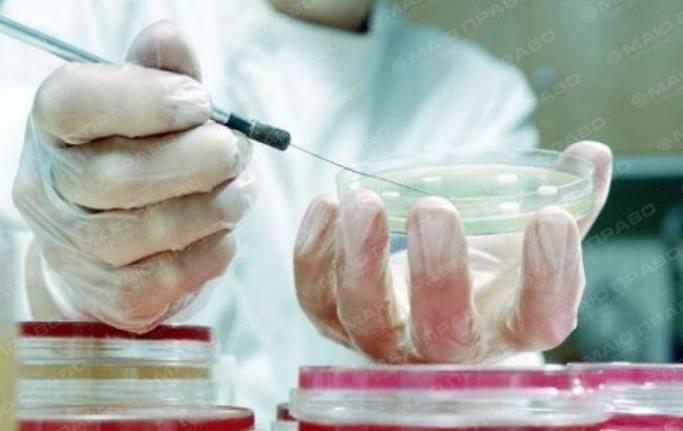
Свежие новости: На Николаевщине зафиксировали еще одну смерть от гриппа

Происшествия | Николаев, 5 Января, 2017
На Николаевщине зафиксировали еще одну смерть от гриппа
В Николаевской области на минувшей неделе (25 декабря – 1 января) зафиксировали смертельный случай заболевания гриппом.
Об этом сообщили в пресс-службе Министерства здравоохранения Украины.
Кроме того, на остальной территории Украины зафиксировано еще пять летальных случаев заболевания гриппом – три во Львовской области и по одному в Полтавской и Запорожской областях.
«За отчетную неделю гриппом и ОРВИ заболели 369 тысяч 151 человек, из них 57,8% - дети в возрасте до 17 лет. Тенденция к росту заболеваемости уменьшилась, специалисты связывают это с новогодними праздниками и каникулами в учебных заведениях. Самый высокий показатель заболеваемости гриппом и ОРВИ зарегистрирован в Киевской, наименьший – в Луганской областях. Интенсивные показатели заболеваемости превысили эпидемические пороги в 21 области Украины и Киеве. Только в Луганской, Ивано-Франковской, Донецкой и Харьковской областях фиксируют показатели ниже эпидемического уровня».
«Темп прироста больных среди взрослых и детей до 17 лет уменьшился на 3% и 17,6% соответственно. Среди лиц, которые обратились за медицинской помощью, уменьшилась потребность в госпитализации на 5,9%. В структуре выявленных респираторных вирусов доминируют вирусы гриппа А», - отмечено в сообщении.
Источник: news.pn
Читайте также
В Николаевской области выявлено 537 новых случаев COVID-19
В Первомайске из-за аварийного отключения пропал свет в родительном отделении стационара
В Первомайске из-за аварийного отключения пропал свет в родительном отделении стационара ... Читать дальше













